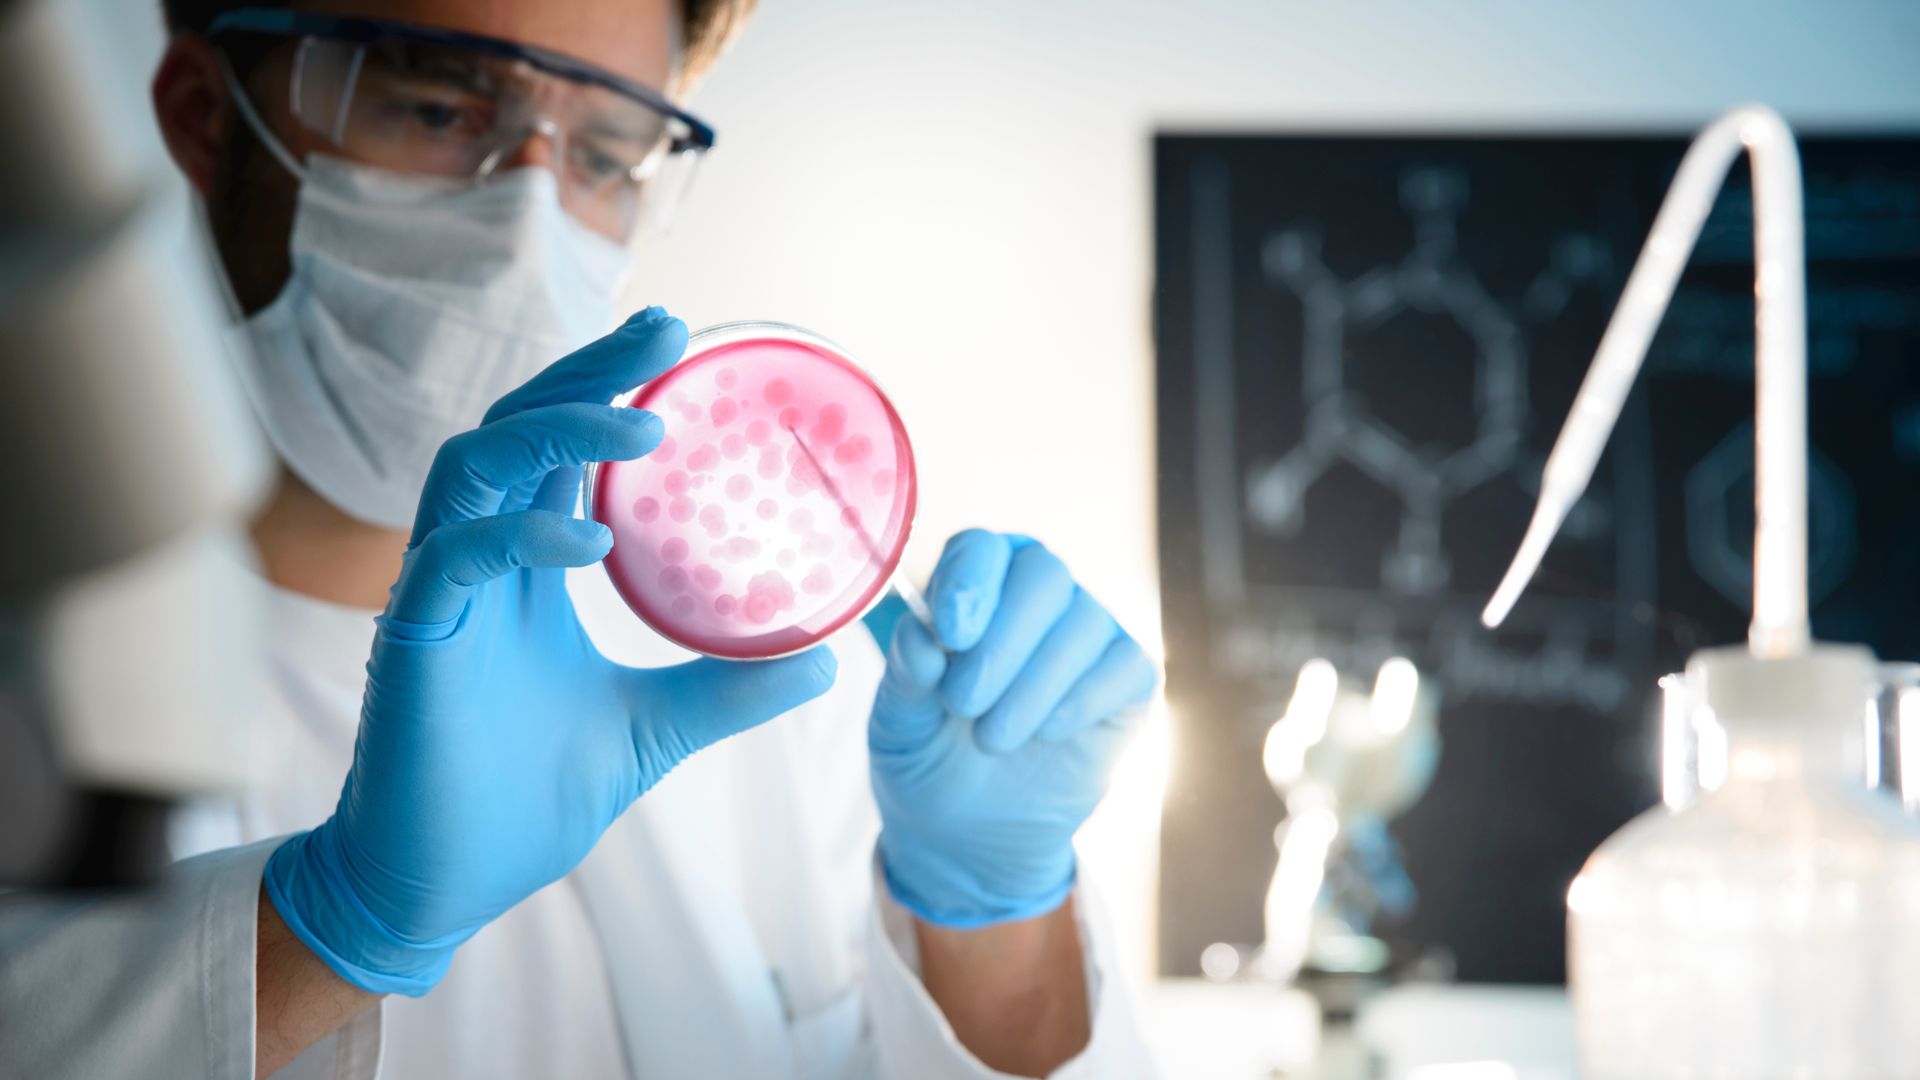
Microbiologie lab waar ze micro-testing uitvoeren

Toegepaste Microbiologie
In de voedingsindustrie heeft microbiologie niet alleen te maken met hygiëne, maar speelt het ook een sleutelrol in productietechnologie. Onze training “Toegepaste Microbiologie” geeft je de basis die je nodig hebt om micro-organismen te herkennen, te begrijpen en effectief te beheersen in jouw werkomgeving. Zo versterk je de betrouwbaarheid en kwaliteit van je processen - met direct toepasbare kennis.
Waarom deze training?
- Essentiële kennis op zak – Je krijgt een introductie in microbiologie, leert welke micro-organismen je waarschijnlijk tegenkomt, kent relevante vaktermen en weet waar je op moet letten bij beheersing, monstername en interpretatie van analyses.
- Gidsende focus op praktijk en wetgeving – Je wordt voorbereid om microbiologische inzichten te vertalen naar je eigen werkcontext—zodat je hygiëne- en kwaliteitsprocessen met vertrouwen kunt uitvoeren en verantwoorden.
- Van theorie naar zelfstandigheid – Na deze training ben je in staat om microbiologische uitdagingen in jouw organisatie te herkennen, te beoordelen en te vertalen naar effectieve beheersmaatregelen.
Wat ga je leren?
- Een heldere introductie tot microbiologie, inclusief de eigenschappen van veelvoorkomende micro-organismen en het belang van pathogenengroei in food managers’ processen.
- Inzicht in terminologie, keuze en aansturing van laboratoria, monsternamecyclus, en het correct interpreteren van analyseresultaten - altijd in samenhang met actuele wet- en regelgeving.
- Ruimte voor praktijkvraagstukken: je eigen case kun je minimaal één week vooraf insturen, zodat de trainer deze tijdens de sessie behandelt.
Per persoon
Demo video
Locatie
Trainingen worden verzorgd op meerdere manieren, natuurlijk rekening houdend met eventuele extra kosten die dat meebrengt. Samen zoeken we een oplossing die het beste past.
Trainingsvorm
Locatie Mechelen, op uw locatie, in uw regio, 1-op-1 coaching
Doelgroep
Talen
Programma
Deze training duurt 1 dag (6 uur), tijden in overleg met de opdrachtgever.
over ons als trainer
Wij zijn adviseurs én opleiders
Onze trainingen komen rechtstreeks uit de praktijk. Ontwikkeld en gegeven door specialisten die zelf dagelijks klanten begeleiden. Daarom zit elk programma vol praktijkvoorbeelden, herkenbare situaties en slimme tips. Wij geloven dat leren leuk én effectief moet zijn. Verwacht dus interactieve sessies, persoonlijk afgestemd op uw praktijk en realiteit.
Erkend voor subsidie
Onze trainingen zijn erkend met de Alimento- en Qfor-certificering. Dat betekent dat ze aantoonbaar voldoen aan hoge standaarden op het gebied van klanttevredenheid, inhoud, didactische kwaliteit en resultaatgerichtheid. Dankzij deze erkenning komen zowel onze in-company als open trainingen in aanmerking voor subsidie. Een onafhankelijk bewijs dat u bij ons investeert in trainingen met kwaliteit én impact.






